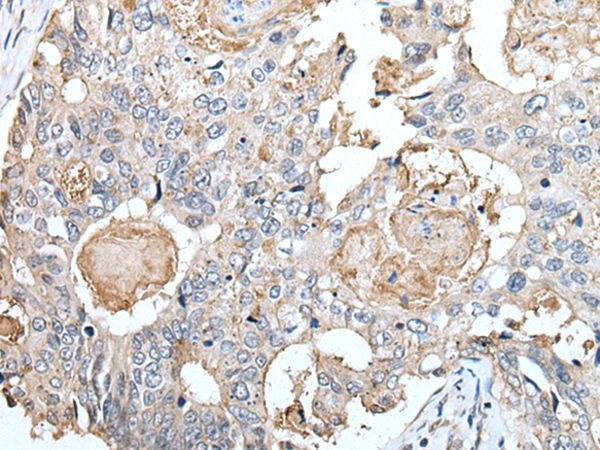
Claudin 6 Antibody in Immunohistochemistry (Paraffin) (IHC (P))

Search
Invitrogen
Claudin 6 Polyclonal Antibody
{{$productOrderCtrl.translations['antibody.pdp.commerceCard.promotion.promotions']}}
{{$productOrderCtrl.translations['antibody.pdp.commerceCard.promotion.viewpromo']}}
{{$productOrderCtrl.translations['antibody.pdp.commerceCard.promotion.promocode']}}: {{promo.promoCode}} {{promo.promoTitle}} {{promo.promoDescription}}. {{$productOrderCtrl.translations['antibody.pdp.commerceCard.promotion.learnmore']}}
图: 1 / 2
Claudin 6 Antibody (PA5-67557) in IHC (P)


Please note: We are reviewing Western blot images included in the antibody testing data in our catalog, including those provided by third parties. Unless expressly labeled or annotated as “raw-unedited”, Western blot images included in the antibody testing data in our catalog may have been edited, optimized or otherwise adjusted for presentation.
产品信息
PA5-67557
种属反应
已发表种属
宿主/亚型
分类
类型
抗原
偶联物
形式
浓度
规格
纯化类型
保存液
内含物
保存条件
运输条件
RRID
靶标信息
Tight junctions represent one mode of cell-to-cell adhesion in epithelial or endothelial cell sheets, forming continuous seals around cells and serving as a physical barrier to prevent solutes and water from passing freely through the paracellular space. These junctions are comprised of sets of continuous networking strands in the outwardly facing cytoplasmic leaflet, with complementary grooves in the inwardly facing extracytoplasmic leaflet. This gene encodes a component of tight junction strands, which is a member of the claudin family. The protein is an integral membrane protein and is one of the entry cofactors for hepatitis C virus. The gene methylation may be involved in esophageal tumorigenesis. This gene is adjacent to another family member CLDN9 on chromosome 16.
仅用于科研。不用于诊断过程。未经明确授权不得转售。
生物信息学
蛋白别名: Claudin-6; Claudin6; CLD6; Skullin; transmembrane protein; unnamed protein product
基因别名: CLDN6; UNQ757/PRO1488
Entrez Gene ID: (Human) 9074